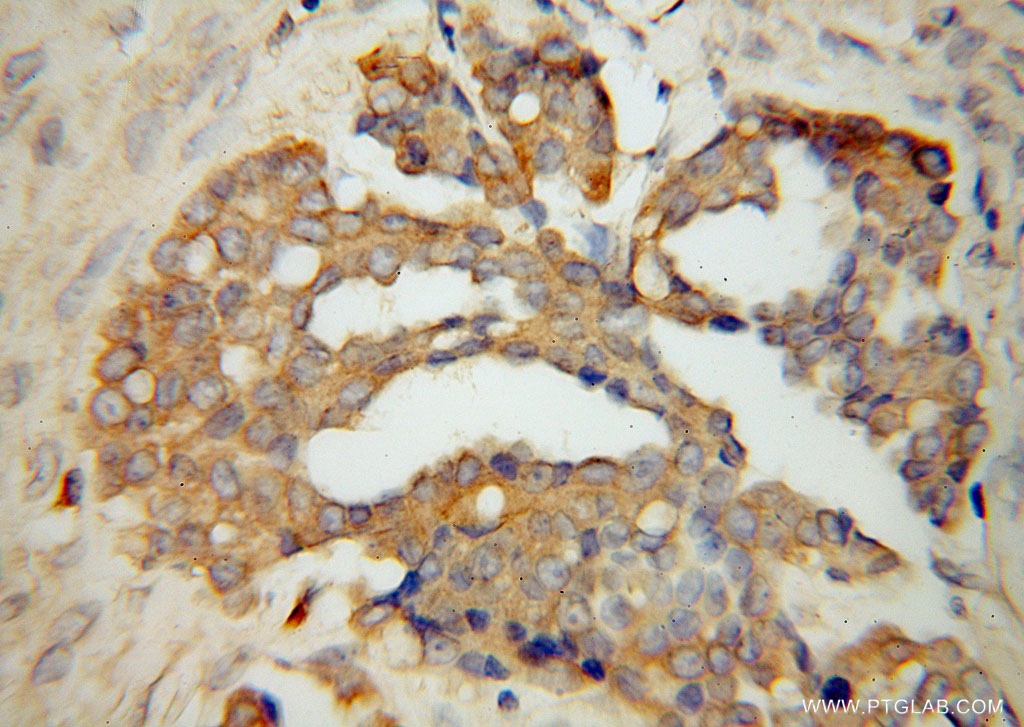

TrpRS抗体
产品名称: TrpRS抗体
英文名称: TrpRSAntibody
产品编号: XY 16081-1
产品价格: null
产品产地: 中国/美国
品牌商标: XYbscience
更新时间: 2023-08-17T09:55:27
使用范围: WB,ELISA,IHC-P,IHC-F,IF
- 联系人 : 徐经理
- 地址 : 上海市闵行莘庄工业区春东路508号A1-2F
- 邮编 : 200612
- 所在区域 : 上海
- 电话 : 152****8802 点击查看
- 传真 : 点击查看
- 邮箱 : shxysw02@163.com
- 二维码 : 点击查看
TRPRS抗体Applications
IP = Immunoprecipitation
XY264Hu21 羰基还原酶3(CBR3)单克隆抗体 Monoclonal Antibody to Carbonyl Reductase 3 (CBR3) Homo sapiens (Hukl)
XY293Hu21 封闭蛋白3(CLDN3)单克隆抗体 Monoclonal Antibody to Claudin 3 (CLDN3) Homo sapiens (Hukl)
XY293Ra21 封闭蛋白3(CLDN3)单克隆抗体 Monoclonal Antibody to Claudin 3 (CLDN3) Rattus norvegicus (Rat)
XY294Hu21 封闭蛋白4(CLDN4)单克隆抗体 Monoclonal Antibody to Claudin 4 (CLDN4) Homo sapiens (Hukl)
XY294Ra21 封闭蛋白4(CLDN4)单克隆抗体 Monoclonal Antibody to Claudin 4 (CLDN4) Rattus norvegicus (Rat)
XY295Hu21 封闭蛋白5(CLDN5)单克隆抗体 Monoclonal Antibody to Claudin 5 (CLDN5) Homo sapiens (Hukl)
XY295Ra21 封闭蛋白5(CLDN5)单克隆抗体 Monoclonal Antibody to Claudin 5 (CLDN5) Rattus norvegicus (Rat)
XY296Ra21 封闭蛋白16(CLDN16)单克隆抗体 Monoclonal Antibody to Claudin 16 (CLDN16) Rattus norvegicus (Rat)
XY297Ra21 封闭蛋白7(CLDN7)单克隆抗体 Monoclonal Antibody to Claudin 7 (CLDN7) Rattus norvegicus (Rat)
XY299Hu21 封闭蛋白11(CLDN11)单克隆抗体 Monoclonal Antibody to Claudin 11 (CLDN11) Homo sapiens (Hukl)
XY303Hu21 细胞因子受体样因子1(CRLF1)单克隆抗体 Monoclonal Antibody to Cytokine Receptor Like Factor 1 (CRLF1) Homo sapiens (Hukl)
XY303Ra21 细胞因子受体样因子1(CRLF1)单克隆抗体 Monoclonal Antibody to Cytokine Receptor Like Factor 1 (CRLF1) Rattus norvegicus (Rat)
XY304Hu21 氯化物细胞内通道蛋白4(CLIC4)单克隆抗体 Monoclonal Antibody to Chloride Intracellular Channel Protein 4 (CLIC4) Homo sapiens (Hukl)
XY315Ra21 羧肽酶A1(CPA1)单克隆抗体 Monoclonal Antibody to Carboxypeptidase A1, Pancreatic (CPA1) Rattus norvegicus (Rat)
XY316Ra21 羧肽酶A2(CPA2)单克隆抗体 Monoclonal Antibody to Carboxypeptidase A2, Pancreatic (CPA2) Rattus norvegicus (Rat)
XY317Hu21 羧肽酶A4(CPA4)单克隆抗体 Monoclonal Antibody to Carboxypeptidase A4 (CPA4) Homo sapiens (Hukl)
XY320Ra21 羧肽酶B1(CPB1)单克隆抗体 Monoclonal Antibody to Carboxypeptidase B1, Tissue (CPB1) Rattus norvegicus (Rat)
XY322Hu21 羧肽酶E(CPE)单克隆抗体 Monoclonal Antibody to Carboxypeptidase E (CPE) Homo sapiens (Hukl)
XY324Ra21 羧肽酶N2(CPN2)单克隆抗体 Monoclonal Antibody to Carboxypeptidase N2 (CPN2) Rattus norvegicus (Rat)
XY326Hu21 羧肽酶Z(CPZ)单克隆抗体 Monoclonal Antibody to Carboxypeptidase Z (CPZ) Homo sapiens (Hukl)
XY331Hu21 细胞维甲酸结合蛋白2(CRABP2)单克隆抗体 Monoclonal Antibody to Cellular Retinoic Acid Binding Protein 2 (CRABP2) Homo sapiens (Hukl)
XY332Hu21 复合素2(CPLX2)单克隆抗体 Monoclonal Antibody to Complexin 2 (CPLX2) Homo sapiens (Hukl)
XY335Hu21 半胱氨酸甘氨酸丰富蛋白1(CSRP1)单克隆抗体 Monoclonal Antibody to Cysteine And Glycine Rich Protein 1 (CSRP1) Homo sapiens (Hukl)